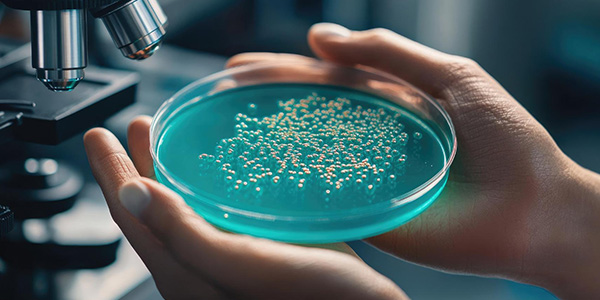

Welcome to surrogacy centre india
Surrogacy Centre India is a legally compliant fertility and surrogacy centre offering ethical and altruistic surrogacy services in accordance with the Surrogacy (Regulation) Act, 2021 and the Assisted Reproductive Technology (Regulation) Act, 2021.
From initial consultation to delivery and post-birth legal support, we follow a transparent, safe, and compassionate approach to help eligible intended parents pursue parenthood within the framework of Indian law.
Book Appointment Explore Our Services
Surrogacy Centre India is one of the leading centers in India offering high-quality, safe, and extremely successful Blastocyst Culture treatments. With modern embryology laboratories, highly skilled IVF experts, and accurate monitoring of embryos, we assist couples in improving their chances of pregnancy by ensuring a healthier embryo selection. Our procedure is simple and well-organized, as well as made to ensure the highest level of comfort of use. With 25+ years of experience and a plethora of successful treatments, Surrogacy Centre India is trusted by couples throughout India and across the globe.
Delhi
Blastocyst Culture is suitable for couples who want to have a better selection of embryos and a better rate of success in IVF. This is a good option for couples who have repeatedly failed IVF attempts, women with a good ovarian response, or couples seeking a one-embryo transfer to decrease the number of pregnancies. It can also be beneficial for people who use frozen embryos from donors, donor eggs, or people who want more advanced methods to create more robust, healthier embryos. This technique is the most effective method for better implantability.
Book Appointment Call +91 70707 04855

Packages
The cost of Blastocyst Culture treatment starts at Rs. 25,000. Surrogacy Centre India provides transparent and reasonable pricing, without hidden costs. The costs are explained in consultations to help couples make an informed decision regarding the most appropriate treatment choice.
Features
Medicines can aid in producing healthy eggs.
Eggs can be collected by a quick, painless procedure that is painless.
Best-quality sperm are selected in the lab.
Eggs and sperm are mixed to aid in embryo development.
The embryos are then cultured for five days prior to reaching an embryonic blastocyst condition.
The most powerful and healthy blastocysts can easily be identified.
The blastocyst is implanted in the uterus.
The pregnancy tests are checked 12-14 days after the birth.
Features
Blastocysts implant better than day-3 embryos
The strongest embryos are the ones that remain viable until the day 5 mark, and improve results
A strong blastocyst can reduce the requirement for multiple transfers
The blastocyst stage of transfer naturally corresponds with the body's rhythm.
Blastocysts can be frozen and thawed more efficientlys
Improves chances for couples who have had unsuccessful IVF attempts.

Blastocyst Culture is more successful when compared to conventional day-to-day embryo transfer. At Surrogacy Centre India, the success rates vary between 60-75% depending on egg quality and general fertility health. Since only embryos with a strong constitution are able to reach the blastocyst stage in development, their likelihood of being related to implantation and pregnancy is greater. Our advanced labs and continuous monitoring boost the performance for our clients.
Sperm retrieval procedures are mostly safe, but some risks, though minor, may still happen:


WHY CHOOSE US
Due to its proficiency, modern methods, and patient-centered approach in male infertility treatment, Surrogacy Centre India has gained trust all over the world:
BABIES
MEDICAL STAFF
GLOBAL PATIENTS
Patient First Approach
PEOPLE ALSO ASK
It is a technique that allows embryos to grow for approximately five days before they attain the stage of blastocyst. This is to select the healthiest embryo to transfer.
Yes, blastocysts have a greater likelihood of successfully implanting. This is often the reason for higher pregnancy rates.
Yes, it is being closely controlled by fertility specialists. Each step is carefully managed to get the most effective results.
In most cases, there is only one blastocyst transferred. This reduces the chance of having multiple births.
Yes, frozen blastocysts are extremely useful to aid in IVF. They are highly successful following thawing.